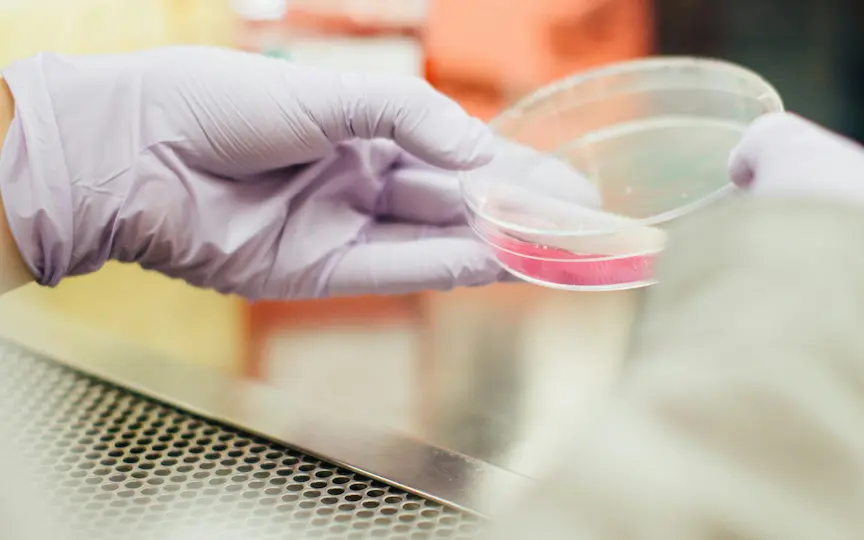

Don’t invest unless you’re prepared to lose all the money you invest. This is a high-risk investment, and you are unlikely to be protected if something goes wrong.
Take two mins to learn more
Don’t invest unless you’re prepared to lose all the money you invest. This is a high-risk investment, and you are unlikely to be protected if something goes wrong.
Take two mins to learn more
Don’t invest unless you’re prepared to lose all the money you invest. This is a high-risk investment, and you are unlikely to be protected if something goes wrong.
Take two mins to learn more
Investment Track Record
Investment Track Record
Investment Track Record
We back founders in:
We back founders in:
We back founders in:
Life Science
Life Science
Food & Agriculture
Food & Agriculture
Sustainable Materials
Sustainable Materials
Hardware & Software
Hardware & Software
Advanced Manufacturing
Advanced Manufacturing
Descycle
Revolutionising electronic waste recycling, Descycle employs Deep Eutectic Solvents for an eco-friendly, swift, and capital-efficient process. With disruptive environmental and economic advantages, Descycle leads the way in sustainable solutions for the electronic waste market.
Why did we invest in Descycle?
Experienced and well-balanced management team.
Strategic alignment and value-add through scale up support from CPI.
Targeting a well-defined and clear need for innovation in a growing market area.
Joint Venture Agreement in place with a UK e-waste processing facility.
High impact potential with sustainability at the core of business activities.
Acquisitive market with trade acquirers paying premium prices for strategic assets.



Descycle
Revolutionising electronic waste recycling, Descycle employs Deep Eutectic Solvents for an eco-friendly, swift, and capital-efficient process. With disruptive environmental and economic advantages, Descycle leads the way in sustainable solutions for the electronic waste market.
Why did we invest in Descycle?
Experienced and well-balanced management team.
Strategic alignment and value-add through scale up support from CPI.
Targeting a well-defined and clear need for innovation in a growing market area.
Joint Venture Agreement in place with a UK e-waste processing facility.
High impact potential with sustainability at the core of business activities.
Acquisitive market with trade acquirers paying premium prices for strategic assets.



Descycle
Revolutionising electronic waste recycling, Descycle employs Deep Eutectic Solvents for an eco-friendly, swift, and capital-efficient process. With disruptive environmental and economic advantages, Descycle leads the way in sustainable solutions for the electronic waste market.
Why did we invest in Descycle?
Experienced and well-balanced management team.
Strategic alignment and value-add through scale up support from CPI.
Targeting a well-defined and clear need for innovation in a growing market area.
Joint Venture Agreement in place with a UK e-waste processing facility.
High impact potential with sustainability at the core of business activities.
Acquisitive market with trade acquirers paying premium prices for strategic assets.




Qkine
At the forefront of stem cell therapy and regenerative medicine, Qkine manufactures high-purity, animal-free growth factors. Their expertise in protein purification and structural biology has confirmed their status as a key player in the growth factor market, with over 40 products on the market.
Why did we invest in Qkine?
Experienced female CEO with a proven track record of laboratory and manufacturing growth.
Growing and multi-faceted markets with multiple areas of expansion.
Over 40 products on the market supported by a strong R&D pipeline.
Credible investor base.
Alignment with CPI’s technical capabilities and areas of strategic focus.

Qkine
At the forefront of stem cell therapy and regenerative medicine, Qkine manufactures high-purity, animal-free growth factors. Their expertise in protein purification and structural biology has confirmed their status as a key player in the growth factor market, with over 40 products on the market.
Why did we invest in Qkine?
Experienced female CEO with a proven track record of laboratory and manufacturing growth.
Growing and multi-faceted markets with multiple areas of expansion.
Over 40 products on the market supported by a strong R&D pipeline.
Credible investor base.
Alignment with CPI’s technical capabilities and areas of strategic focus.
Qkine
Qkine
At the forefront of stem cell therapy and regenerative medicine, Qkine manufactures high-purity, animal-free growth factors. Their expertise in protein purification and structural biology has confirmed their status as a key player in the growth factor market, with over 40 products on the market.
At the forefront of stem cell therapy and regenerative medicine, Qkine manufactures high-purity, animal-free growth factors. Their expertise in protein purification and structural biology has confirmed their status as a key player in the growth factor market, with over 40 products on the market.


Why did we invest in Qkine?
Experienced female CEO with a proven track record of laboratory and manufacturing growth.
Experienced female CEO with a proven track record of laboratory and manufacturing growth.
Growing and multi-faceted markets with multiple areas of expansion.
Growing and multi-faceted markets with multiple areas of expansion.
Over 40 products on the market supported by a strong R&D pipeline.
Over 40 products on the market supported by a strong R&D pipeline.
Credible investor base.
Credible investor base.
Alignment with CPI’s technical capabilities and areas of strategic focus.
Alignment with CPI’s technical capabilities and areas of strategic focus.
Q5D
Redefining additive manufacturing, Q5D's 5-axis robotic platform automates wiring and printed electronics, significantly reducing costs and reliance on manual labour. Their technology is pivotal in meeting the increasing demand for electrical connections in the automotive industry.
Why did we invest in Q5D?
Innovative and novel technology developed from commercial insights.
Clear market needs with a proven application of technology.
Commercial traction through projects with corporates across various sectors.
Alignment with CPI’s Formulation capabilities.
Credible investor base.



Q5D
Redefining additive manufacturing, Q5D's 5-axis robotic platform automates wiring and printed electronics, significantly reducing costs and reliance on manual labour. Their technology is pivotal in meeting the increasing demand for electrical connections in the automotive industry.
Why did we invest in Q5D?
Innovative and novel technology developed from commercial insights.
Clear market needs with a proven application of technology.
Commercial traction through projects with corporates across various sectors.
Alignment with CPI’s Formulation capabilities.
Credible investor base.



Q5D
Redefining additive manufacturing, Q5D's 5-axis robotic platform automates wiring and printed electronics, significantly reducing costs and reliance on manual labour. Their technology is pivotal in meeting the increasing demand for electrical connections in the automotive industry.
Why did we invest in Q5D?
Innovative and novel technology developed from commercial insights.
Clear market needs with a proven application of technology.
Commercial traction through projects with corporates across various sectors.
Alignment with CPI’s Formulation capabilities.
Credible investor base.




MarraBio
A pioneer in engineering multimeric proteins, MarraBio utilises a proprietary E. coli-based technology for a diverse number of applications. From cell culture reagents to low-cost growth factors for cultivated meat production, the company is poised to make a profound impact in the biotechnology arena.
Why did we invest in MarraBio?
Innovative and novel technology developed from university research.
Strategic alignment with CPI.
Strong management team, integral to the technical development.
Expansive market with early market interest.

MarraBio
A pioneer in engineering multimeric proteins, MarraBio utilises a proprietary E. coli-based technology for a diverse number of applications. From cell culture reagents to low-cost growth factors for cultivated meat production, the company is poised to make a profound impact in the biotechnology arena.
Why did we invest in MarraBio?
Innovative and novel technology developed from university research.
Strategic alignment with CPI.
Strong management team, integral to the technical development.
Expansive market with early market interest.
MarraBio
MarraBio
A pioneer in engineering multimeric proteins, MarraBio utilises a proprietary E. coli-based technology for a diverse number of applications. From cell culture reagents to low-cost growth factors for cultivated meat production, the company is poised to make a profound impact in the biotechnology arena.
A pioneer in engineering multimeric proteins, MarraBio utilises a proprietary E. coli-based technology for a diverse number of applications. From cell culture reagents to low-cost growth factors for cultivated meat production, the company is poised to make a profound impact in the biotechnology arena.
Why did we invest in MarraBio?
Innovative and novel technology developed from university research.
Innovative and novel technology developed from university research.
Strategic alignment with CPI.
Strategic alignment with CPI.
Strong management team, integral to the technical development.
Strong management team, integral to the technical development.
Expansive market with early market interest.
Expansive market with early market interest.


INFORMATION MEMORANDUM
Download Investment Brochure
We are delighted to share the latest edition of the EverQuest EIS Fund Information Memorandum.
By choosing EverQuest as your investment partner, you become integral to our aim to have a real contribution to our world.
By submitting you agree that the email provided is subject to our Privacy Policy.

Download Investment Brochure
We are delighted to share the latest edition of the EverQuest EIS Fund Information Memorandum.
By choosing EverQuest as your investment partner, you become integral to our aim to have a real contribution to our world.
By submitting you agree that the email provided is subject to our Privacy Policy.

Download Investment Brochure
We are delighted to share the latest edition of the EverQuest EIS Fund Information Memorandum.
By choosing EverQuest as your investment partner, you become integral to our aim to have a real contribution to our world.
By submitting you agree that the email provided is subject to our Privacy Policy.
